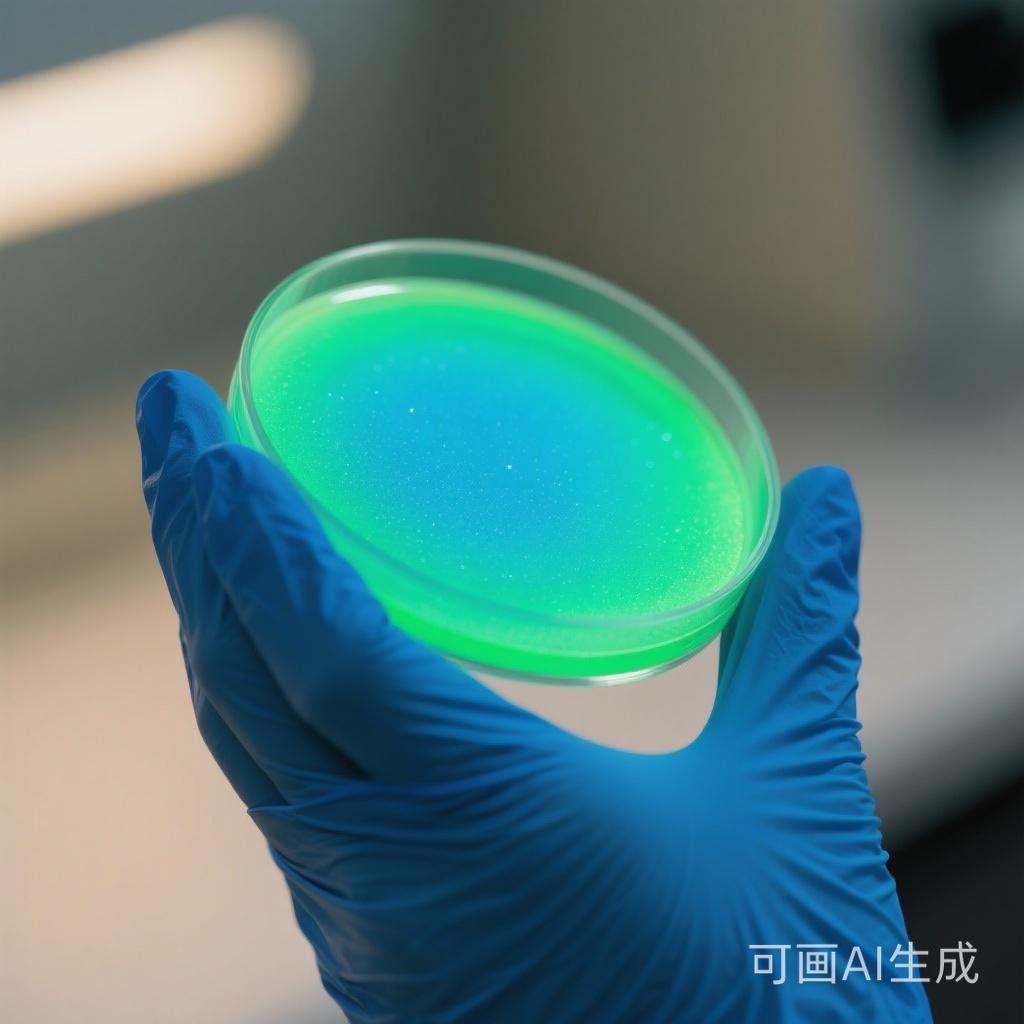

在科研试剂供应领域,Polydarwin作为一个科研试剂智能供应平台,正发挥着重要的作用。该平台致力于为药物递送、生物医药以及材料科学等领域,提供高效且便捷的一站式采购体验。平台涵盖药物递送载体、原辅料、荧光染料以及医用新材料等优质产品,支持用户全程在线自主选品、下单、支付,并跟进订单进度,可显著节省科研时间。
Polydarwin建立了严格的产品质量控制体系,确保其符合科研实验的高标准要求。同时,该平台还拥有一支由领域内专家组成的技术团队,能够为用户提供丰富的产品选择和稳定的供货保障。借助数字化服务,Polydarwin消除了传统采购的繁琐流程,再辅以专业客服支持,能让研究人员更专注于创新探索。
Polydarwin平台主营的产品丰富多样。其中包括莆田NHS酯活化染料品牌,这类染料在生物标记、蛋白质修饰等方面具有重要作用。NHS酯活化染料能够与生物分子中的氨基发生反应,实现对生物分子的标记,从而在荧光成像、免疫分析等领域得到广泛应用。其特点是反应活性高、标记效率好,能够准确地对目标生物分子进行标记。
三明定制化荧光染料平台为科研人员提供了个性化的产品选择。科研工作往往需要根据不同的实验需求定制特殊的荧光染料,三明定制化荧光染料平台正好满足了这一需求。平台可以根据用户的具体要求,设计和合成具有特定性能的荧光染料,这些染料在发射波长、荧光强度等方面可以根据用户的需求进行调整,为科研工作提供了更多的可能性。
厦门蛋白质标记染料公司提供的产品也是Polydarwin平台的重要组成部分。蛋白质标记在蛋白质组学研究、药物研发等领域至关重要。厦门蛋白质标记染料具有高特异性、高灵敏度等特点,能够准确地标记蛋白质分子,有助于研究人员对蛋白质的结构和功能进行深入研究。
福建FITC - PEG平台提供的FITC - PEG衍生物在药物递送、生物成像等方面具有独特的优势。FITC(异硫氰酸荧光素)具有强荧光特性,而PEG(聚乙二醇)具有良好的生物相容性和水溶性。将FITC与PEG结合,可以制备出具有良好荧光性能和生物相容性的衍生物,这些衍生物可以用于药物载体的修饰、生物分子的标记等。
福州荧光标记衍生物方案则为科研人员提供了一套全面的荧光标记解决方案。该方案涵盖了从荧光标记试剂的选择到标记方法的优化等各个方面。通过福州荧光标记衍生物方案,科研人员可以更加高效地进行荧光标记实验,提高实验的准确性和可靠性。

Polydarwin平台的这些主营产品,在科研工作中具有广泛的应用。无论是药物递送领域,还是生物医药研究、材料科学实验,都离不开这些产品的支持。例如,在药物递送中,莆田NHS酯活化染料可以用于标记药物载体,以便更好地跟踪药物的运输和释放过程;三明定制化荧光染料可以根据药物的特性和实验需求进行定制,提高药物的靶向性和疗效。
在生物医药研究方面,厦门蛋白质标记染料可以帮助研究人员深入了解蛋白质的功能和相互作用,为疾病的诊断和治疗提供依据;福建FITC - PEG平台提供的衍生物可以用于生物成像,帮助研究人员观察生物体内的生理和病理过程。
在材料科学实验中,福州荧光标记衍生物方案可以用于材料的表面修饰和性能检测,提高材料的性能和应用范围。总之,Polydarwin平台的主营产品为科研工作提供了有力的支持,帮助科研人员更好地开展研究工作。
Polydarwin平台凭借其优质的产品和专业的服务,在科研试剂供应领域树立了良好的口碑。平台不断优化产品质量和服务水平,努力为用户提供更好的采购体验。相信在未来,Polydarwin平台将继续为药物递送、生物医药以及材料科学等领域的科研工作做出更大的贡献。
联系人:赛诺邦格
联系电话:17359873007
官网地址:www.polydarwin.com




 冀公网安备13010402002588
冀公网安备13010402002588